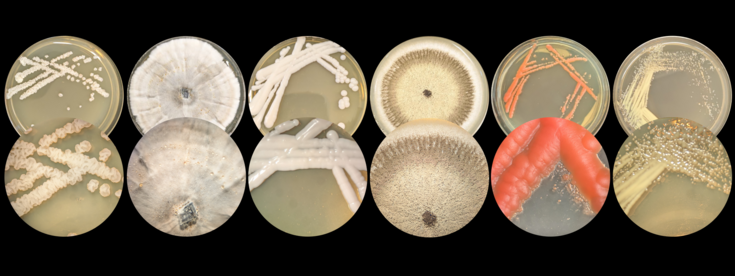

Probeseite
Nature has already solved many of the challenges faced in modern industrial biotechnology. Over millions of years, microorganisms have evolved to thrive in diverse ecological niches, equipping them with remarkable capabilities that can be harnessed for industrial applications.
In our lab, we explore and utilize this natural biodiversity to discover and develop microbial cell factories that are ideally suited for real-world production conditions. We work with a wide variety of organisms including bacteria, yeasts, and filamentous fungi from diverse environmental and industrial origins.
By combining nature’s inherent diversity with state-of-the-art metabolic engineering techniques, we create robust strains and design bioprocesses that closely match industrial needs. This strategy allows us to convert renewable resources into valuable chemicals such as bioplastics or biofuels, contributing to the global transition toward a carbon-neutral and sustainable society.
Nature has already solved many of the challenges faced in modern industrial biotechnology. Over millions of years, microorganisms have evolved to thrive in diverse ecological niches, equipping them with remarkable capabilities that can be harnessed for industrial applications.
In our lab, we explore and utilize this natural biodiversity to discover and develop microbial cell factories that are ideally suited for real-world production conditions. We work with a wide variety of organisms including bacteria, yeasts, and filamentous fungi from diverse environmental and industrial origins.
By combining nature’s inherent diversity with state-of-the-art metabolic engineering techniques, we create robust strains and design bioprocesses that closely match industrial needs. This strategy allows us to convert renewable resources into valuable chemicals such as bioplastics or biofuels, contributing to the global transition toward a carbon-neutral and sustainable society.